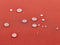
TOSCANA - Tuinbankkussen - Donkerrood - Polyester

TOSCANA - Tuinbankkussen - Donkerrood - Polyester
Description
TOSCANA - Tuinbankkussen - Donkerrood - PolyesterVerander je buitenruimte met het TOSCANA tuinbankkussen in een prachtige donkerrode kleur. Dit zitkussen is ontworpen om je buitenmeubilair een frisse uitstraling te geven en biedt een comfortabele plek om te ontspannen. Gemaakt van zachte polyester stof, zorgt het kussen voor een uitnodigende sfeer in je tuin of op je terras. Of je nu een boek leest of geniet van een kopje koffie, dit kussen maakt je buitenervaring compleet.
Het TOSCANA tuinbankkussen is niet alleen stijlvol, maar ook praktisch. Het kussen is waterdicht en onderhoudsvriendelijk, waardoor je het met een gerust hart buiten kunt laten liggen, zelfs bij een lichte regenbui. De hoogwaardige polyester stof is UV-bestendig, wat betekent dat de kleur mooi blijft, zelfs na langdurige blootstelling aan de zon. Met de handige touwtjes bevestig je het kussen eenvoudig aan je tuinbank, zodat het altijd op zijn plek blijft.
- Afmetingen: 169 cm breed, 50 cm diep, 5 cm hoog
- Materiaal: 100% polyester met schuimstof vulling
- Waterdicht en licht waterafstotend
- UV-bestendigheidsklasse 5 (ISO 105-B02)
- Verwijderbare en wasbare kussenhoezen
- Praktische touwtjes voor eenvoudige bevestiging
Om het TOSCANA tuinbankkussen in topconditie te houden, maak je het eenvoudig schoon met een natte spons en een mild schoonmaakmiddel. Voor een grondigere reiniging kun je het oppervlak stofzuigen met een geschikt opzetstuk. Wanneer je het kussen niet gebruikt, is het aan te raden om het op een schone en droge plek te bewaren, zodat het in optimale staat blijft.
- Stijlvol en modern design voor elke tuin
- Comfortabel en uitnodigend voor ontspanning
- Ondersteunt een zorgeloze buitenervaring
- Gemakkelijk te onderhouden en schoon te maken
- Ideaal voor langdurig gebruik in de buitenlucht
- Versterkt de uitstraling van je buitenmeubilair
Voeg het TOSCANA tuinbankkussen vandaag nog toe aan je winkelwagentje en geniet van een comfortabele en stijlvolle buitenervaring!
Specifications
We will keep you informed.
When is avaliable, you will receive an email on .